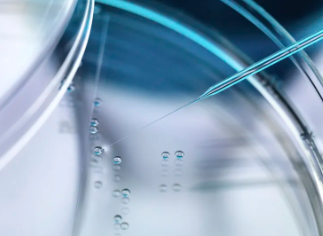
image.png

同濟醫院幹細胞修複費用是多少,其治療效果又如何呢
2024-12-04 16:13:05 來源: 小編 咨詢醫生
幹細胞療法作爲一種前沿的生物技術,近年來在醫學領域備受關注。本文将圍繞“同濟醫院幹細胞修複費用是多少,其治療效果又如何呢”這一問題,爲您詳細介紹同濟醫院幹細胞修複的相關信息。
一、同濟醫院幹細胞修複費用
幹細胞修複費用的确定因素較多,包括患者病情、治療次數、治療方式等。同濟醫院作爲我國知名的三甲醫院,其幹細胞修複費用相對較高。具體費用需根據患者實際情況進行評估,以下是一些影響費用的因素:
1.患者病情:病情較輕的患者,治療費用相對較低;病情較重的患者,治療費用相對較高。
2.治療次數:幹細胞修複通常需要多次治療,治療次數越多,費用越高。
3.治療方式:不同治療方式的費用差異較大,如自體幹細胞移植、異體幹細胞移植等。
二、同濟醫院幹細胞修複治療效果
同濟醫院在幹細胞修複領域擁有豐富的臨床經驗,其治療效果如下:
1.療效顯著:幹細胞修複能夠有效改善患者病情,提高生活質量。對于某些疾病,如神經系統疾病、心血管疾病等,幹細胞修複具有顯著的治療效果。
2.安全性高:同濟醫院采用先進的幹細胞技術,确保治療過程的安全性。同時,醫院擁有一支專業的醫療團隊,爲患者提供全方位的醫療保障。
3.恢複期短:與傳統治療方式相比,幹細胞修複的恢複期較短,患者可在較短時間内恢複正常生活。
以下是一些具體疾病的幹細胞修複治療效果:
1.腦梗塞:幹細胞修複能夠促進神經功能的恢複,提高患者的生活質量。
2.心血管疾病:幹細胞修複能夠修複受損的心肌細胞,改善心髒功能。
3.骨折愈合:幹細胞修複能夠促進骨折部位的愈合,縮短康複周期。
三、結語
同濟醫院幹細胞修複費用雖然相對較高,但治療效果顯著,安全性高。在選擇幹細胞修複治療時,患者應充分了解自身病情,與醫生溝通,制定合适的治療方案。在同濟醫院接受幹細胞修複治療,将爲患者帶來更好的生活質量。
- 2024-11-20除皺針幹細胞價格高嗎,對人體會産生副作用嗎
- 2024-11-02台州人體幹細胞治療價格高嗎?幹細胞價格影響因素有哪些?
- 2024-11-16間質幹細胞注射價格受哪些因素影響,性價比高嗎
- 2024-11-19幹細胞治療腎癌的費用是多少,值得投入嗎
- 2024-10-14治療偏癱的幹細胞費用高嗎?與傳統治療相比優缺點是什麽?
- 2024-11-18幹細胞移植肝髒費用是多少,術後恢複要注意什麽
- 2024-09-17捐造血幹細胞對身體有害嗎,捐造血幹細胞好處和壞處
- 2024-09-04幹細胞制備新技術的優勢及應用前景
- 2024-10-12阜陽造血幹細胞有何功效?适用于哪些疾病治療?
- 2024-09-06牙齒幹細胞存儲有什麽作用,存儲費用多少
- 2024-10-08鹽城幹細胞價格是多少?與效果有何關聯?
- 2024-09-16南通肝硬化幹細胞功效,哪家醫院比較好
- 2024-07-21幹細胞有什麽作用,幹細胞作用效果怎麽樣
- 2024-10-11河南培養幹細胞的價格是多少?與全國相比有何優勢?
- 2024-08-02什麽是造血幹細胞,造血幹細胞移植需要多少錢
- 2024-08-16異體幹細胞的作用和功效,異體幹細胞移植費用詳解
- 2024-08-29幹細胞治療肝硬化費用明細詳解
- 2024-10-04幹細胞移植多長時間就起作用了
